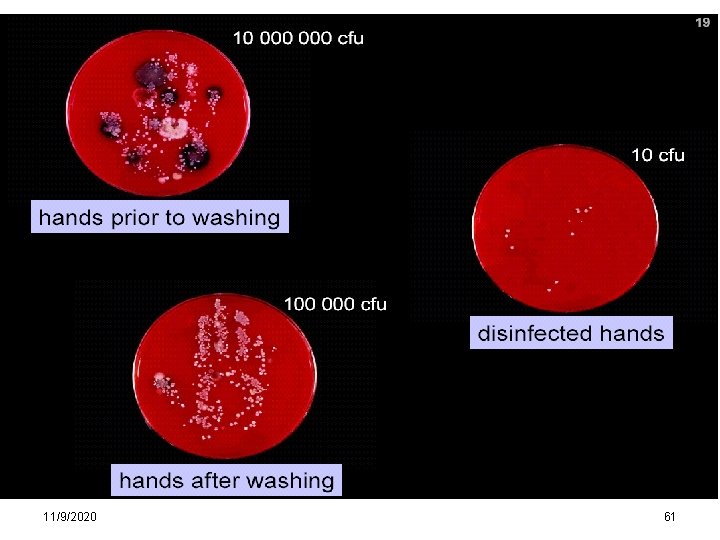
11/9/2020 61

Hastane Enfeksiyonlar ve zolasyon nlemleri r Gr Dr



















































































































- Slides: 115

Hastane Enfeksiyonları ve İzolasyon Önlemleri Öğr. Gör. Dr. F. Özlem ÖZTÜRK

• Nosos: Hastalık • Nosocomium: Hastane • Nozokomiyal: Hastane kökenli veya kaynaklı Nazokomiyal

Hastane İnfeksiyonları-1 • Hastalar hastaneye başvurduktan sonra gelişen ve başvuru anında inkübasyon döneminde olmayan veya hastanede gelişmesine rağmen bazen taburcu olduktan sonra ortaya çıkabilen infeksiyonlardır. • Genellikle hastaneye yattıktan 48 -72 saat sonra ve taburcu olduktan sonra ilk 10 gün içinde gelişen infeksiyonlardır.

Hastane İnfeksiyonları-2 • Ancak enfeksiyonun tipine göre bu tanım değişiklik gösterir. • Örneğin; cerrahi bir girişimi takiben, ilk 30 gün içinde yara bölgesinde gelişen enfeksiyonlar hastane enfeksiyonu kabul edilir.

Hastane İnfeksiyonları-3 • Eğer cerrahi girişim sırasında kalıcı olarak yerleştirilmiş bir yabancı cisim varsa (eklem protezi, protez kalp kapağı gibi) ameliyattan sonraki 1 yıl içinde cerrahi girişim bölgesinde gelişen enfeksiyonlar, hastane enfeksiyonu olarak tanımlanır.

Hastane İnfeksiyonu sıklığı • Hastanede yatan hastaların % 5 -10 kadarında görülmektedir. • Yoğun bakım ünitesinde yatan hastalarda görülme oranı % 20 -30 dolayındadır.

Hastane Enfeksiyonları Tarihçe-1 • 1843 Oliver Wendell Holmes, “Lohusalık Ateşi” nin doktorların ebelerin kontamine olmuş elleriyle yayıldığı hipotezini ileri sürmüş ve bunu klinik gözlem, laboratuvar sonuçları ile kanıtlamıştır.

Hastane Enfeksiyonları Tarihçe-2 • Florance Nightingale 1850’li yıllarda Kırım savaşında enfeksiyonların çevre kirliliğinden kaynaklandığına işaret etmiştir. • Kırım’da 2 yıllık sürede hastaneye temiz besin, temiz su ve temiz çevre sağlayarak ölüm oranını %42’den %2 ye düşürmüştür.

Hastane Enfeksiyonları Tarihçe-3 • Lister 1860’lı yıllarda yara enfeksiyonlarından mo’ların sorumlu olduğunu ifade etmiş. • 1910’lara kadar büyük hastanelerde steril enstrümanlar, eldivenler, maskeler kullanılmaya başlamış. • 1970’lerin başında İngiltere’de ilk enfeksiyon kontrol hemşiresi görevlendirilmiştir.

Hastane Enfeksiyonları Tarihçe-4 • 2005 yılında DSÖ tarafından yeni bir proje başlatıldı. • Projenin sloganı; “Clean Care is Safer Care” “Temiz bakım daha güvenli bakımdır” • Bu projenin bir parçası olan; “Hayat kurtar: Ellerini temizle” başlıklı ‘Save Lives: Clean Your Hands” programı ile çok sayıda ülkede el hijyenine uyumun arttırılmasına yönelik faaliyetler yürütüldü


Hastane Enfeksiyonları Tarihçe-5 • Ülkemizde hastane enfeksiyonları ile ilgili çalışmalar oldukça yenidir. • 1970’lerden sonra enfeksiyon kontrol ekipleri kurulmaya başlanmış. • 2000 yılından bu yana da tüm hastanelerde enfeksiyon kontrol çalışmaları sürmektedir.

Hastane Enfeksiyonları Tarihçe-6 • 2005’de “Yataklı Tedavi Kurumları İşletme Yönetmeliğinde Değişiklik Yapılmasına Dair Yönetmelik” ile Enfeksiyon Kontrol Komitesi hastanelerde zorunlu hale getirildi.

Enfeksiyon Kontrol Komitesinin Yapısı • EKK BAŞKANI – – – – – Başhekim Yardımcısı Cerrahi Bilimler Temsilcisi Dahili Bilimler Temsilcisi Enfeksiyon Kontrol Hekimi Enfeksiyon Kontrol Hemşiresi (Her 250 yatak için 1 hem) Mikrobiyoloji Lab. Temsilcisi Hastane Müdürü Eczane Sorumlusu Başhemşire

EKK Görevleri • Enf. kontrol prog. belirleme, uygulama, • Sürveyans yapmak, 3 ayda bir hastane yönetimine rapor sunmak, • Sağlık çalışanlarına, hastane enf. önlenmesi ile ilgili eğitim yapmak, • Bir enfeksiyon riski belirlendiğinde inceleme yapmak, izolasyon tedbirlerini belirlemek, • Atıklar, çamaşırhane, mutfak için enf. kontrolü denetimi yapmak

ENFEKSİYON KONTROLÜNDE ; En Büyük İdari Yetkiliden, Temizlik Personeline Kadar Tüm Çalışanların, Kendi Görevi Kapsamında Sorumluluğu Vardır 11/9/2020 16

HASTANE ENFEKSİYONU OLUŞUMUNDA PEK ÇOK FAKTÖR ROL OYNAR YATIŞ SÜRESİ İLE, RİSK DOĞRU ORANTILI OLARAK ARTAR 11/9/2020 17

CDC The Hospital Infection Program HASTANE ENFEKSİYONLARI GÖRÜLME HIZI BİR KALİTE İNDİKATÖRÜDÜR. 11/9/2020 18

HASTANE ENFEKSİYONU NEDEN ÖNEMLİDİR 11/9/2020 19

İş gücü kaybı olur 11/9/2020 20

Hastanede Yatış süresi uzar 11/9/2020 21

Laboratuvar tetkikleri artar 11/9/2020 22

Girişimlerde artış olur 11/9/2020 23

Genellikle enfeksiyon etkeninin çoklu antibiyotik direnci olabileceği için tedavileri daha güç ve pahalı olur 11/9/2020 24

PRİMER HASTALIK İYİLEŞSE DE, HASTANE ENFEKSİYONU NEDENİYLE HASTA YAŞAMINI YİTİREBİLİR 11/9/2020 25

Hastane İnfeksiyonlarının Nedenleri 1. Hastanede yapılan invaziv girişimler 2. Temizlik kurallarına dikkat edilmemesi 3. Sağlık çalışanlarının sayısal yetersizliği 4. Hastanın bağışıklık sistemini olumsuz etkileyen faktörler

Hastane İnfeksiyonları • Bir enfeksiyonun HE olup olmadığına klinik gözlem, laboratuvar sonuçları ve diğer hasta kayıtlarının değerlendirilmesi ile karar verilir.

Eksojen bulaş • Hastane ortamında, hasta ile ilişkili olan tüm kişi ve objeler enfeksiyon kaynağıdır • Diğer hastalar • Doktor • Hemşire • Yardımcı personel • Tedavi amaçlı uygulanan kateterler (üriner ve damar) • Solunum desteği • Endoskopi • Cerrahi işlemler • Diğer girişimler 11/9/2020 28

Endojen bulaş • Flora dengesinin bozulması ve/veya içerdiği mikroorganizmanın başka bir vücut bölgesine taşınması ile olur • Flora dengesinin bozulmasında en önemli etken antibiyotik kullanımıdır 11/9/2020 29

KAYNAK İNSAN-OBJELER DİĞER HAVA YOLU DİREKT TEMAS İNDİREKT (Gıda, kan, SOLUNUM Deri-Mukozalar TEMAS IV sıvılar, S pyogenes S aureus Dezenfektan) M tuberculosis KNS Salmonella Legionella Gram negatif Pseudomonas Aspergillus Basiller Gram negatif RSV VRE Basiller Influenza HBV, HCV 11/9/2020 30

HASTANE ENFEKSİYON KLİNİK TABLOLARI • • Bakteriyemi Sepsis Üriner sistem enfeksiyonları Alt solunum sistemi enfeksiyonları Cerrahi alan enfeksiyonları MSS enfeksiyonları Diğer 11/9/2020 31

Nöroloji Yoğun Bakım Ünitesinde Bir Yıllık Hastane Enfeksiyonu Oranları: Patojenik ve Klinik Değerlendirme (Eren F. , Öngün G. , Ural O. , Öztürk Ş. , 2017) Amaç: Hastane enfeksiyonları (HE) özellikle yoğun bakım üniteleri (YBÜ) gibi yüksek riskli alanlarda yatan hasta gruplarında ciddi tehdit oluşturmaktadır. Bu alanlardaki enfeksiyon etkenlerinin tanınması ve bu enfeksiyonların tedavisi hem primer hastalığın prognozu hem de hastanede kalış süresi üzerinde etkilidir. Bu çalışmada nöroloji YBÜ’de (NYBÜ) aktif enfeksiyon surveyans değerlendirmesi yapmayı planladık. Gereç ve Yöntem: NYBÜ’de on iki aylık sürede 291 hasta çalışmaya dahil edilmiştir. Fakültemiz enfeksiyon kontrol komitesi tarafından tutulan kayıtlar “Hastalık Kontrol ve Önleme Merkezi” (Centers for Disease Control and Prevention) tanı kriterlerine göre incelenmiş ve HE tanısı konulmuştur. İzole edilen mikroorganizmalar ve sistemik tutulumları incelenmiştir. Bulgular: NYBÜ’deki enfeksiyonlar tüm HE’lerin %6, 39’unu oluşturmaktadır. Bunlar; deri ve yumuşak doku enfeksiyonları (%3, 13), kan dolaşımı enfeksiyonları (%9, 38), mekanik ventilatörden bağımsız pnömoniler (%9, 38), ventilatör ile ilişkili pnömoniler (%6, 25) ve üriner sistem enfeksiyonlarıdır (ÜSE) (%71, 88). Bu ünitede on iki ayda on dört farklı mikroorganizma tespit edilmiştir. Sonuç: YBÜ’de en sık tespit edilen enfeksiyon ÜSE olduğundan üriner kateter takılması ve bakımında daha dikkatli olunması gerekmektedir. Ayrıca HE’lerin tanınması ve neden olan mikroorganizmaların antibiyotik duyarlılıklarının belirlenmesi hem ampirik tedaviyi belirlemede, hem de mortalite ve morbiditeyi azaltmada oldukça önemlidir.

Hastane Enfeksiyonlarının Önlenmesi-1 • Araçların temizlik, sterilizasyon ve dezenfeksiyonu • El yıkamanın gerekli olduğu durumların bilinmesi, doğru uygulanması • Eldiven ve maske kulllanımının gerekli olduğu durumların bilinmesi, doğru kullanılması

Hastane Enfeksiyonlarının Önlenmesi-2 • Enfekte atıkların toplanması, • Çamaşır ve örtülerin yıkanması • İmmün sistemi baskılanmış ve diğer nedenlerle enfeksiyona duyarlı hasta ya da personelin, bulaşıcı hastalığı olan hastalardan ayrılması • Mutfak temizliği ve yiyeceklerin hazırlanması • Havalandırma sistemleri, laboratuvardaki biyolojik kaplar vs. mühendislik kontrolleri

Enfeksiyon kontrol programı Dezenfeksiyon uygulamaları İzolasyon önlemleri Sürveyans Kateter enf önlenmesi HIV önlenmesi Uygun antibiyotik kullanımı Enfeksiyon kontrolü Hastane temizliği Yoğun bakımda enf kontrolü Dezenfeksiyon sterilizasyon Tıbbi atıklar Kişisel hijyen EL HİJYENİ 11/9/2020 35

Tüm yapılan işlemler sırasında el teması gerektiğinden hemen her aşamada ELLERİN HİJYENİ önemlidir. 11/9/2020 36


NE ZAMAN ELİMİZİ YIKAYALIM? 11/9/2020 38

El Hijyeni Ne Zaman ? ÖNCE SONRA • Hasta ile temas • Hasta çevresindeki yüzeylerle temas • Her tür invaziv girişim • Eldivenlerin çıkartılması • Kan, kanlı sekresyon ile kontamine olma olasılığı olan herhangi bir alet veya objeye temas • Diğer vücut sekresyonları ile temas • Yemek • Tuvalet • Hasta çevresindeki yüzeylerle temas • Her tür invaziv girişim • Eldiven giyme • İlaçların hazırlanması • Yemek • Tuvalet • İşten ayrılma 39

EL HİJYENİ (YIKAMA)NE ZAMAN GEREKLİ? ASEPTİK İŞLEMLERDEN ÖNCE HASTA İLE TEMAS SONRASINDA HASTA İLE TEMAS ÖNCESİNDE VÜCUT SIVILARI İLE TEMAS SONRASINDA 11/9/2020 HASTA ÇEVRESİNDEKİ YÜZEYLERLE TEMAS SONRASINDA 40

El hijyeni ve el yıkama • El yıkama; hastane enfeksiyonlarını önlemede tek başına en etkin ve ucuz yöntemdir • Ne yazık ki, sağlık çalışanları tarafından yeterli sıklık ve etkinlikte uygulanmamaktadır • El yıkama uyumu %10 -30 düzeylerinde saptanmaktadır 11/9/2020 41

Hastane içerisinde çoklu ilaç direnci gösteren mikroorganizmaların hastalar arasında taşınması ve yayılmasında %40 kaynak, sağlık çalışanlarının kirli elleridir. 11/9/2020 42

Deri ve Flora • • • Kafa derisi 1 x 106 Aksilla 5 X 10*5 Abdomen üzeri 4 x 104 Önkol 1 x 104 CFU/cm 2 bakteri Sağlık personelinin ellerindeki bakteri sayısı 5 X 10*6 cfu/cm 2 11/9/2020 43


a-Kalıcı flora • Patojen bakterilere karşı konağın savunmasında etkilidir. • El yıkama işlemlerinden sonra bu bakteri topluluğunda azalma olmaz • Bu floranın üyeleri KNS, Mikrococcus, Propionibacterium ve Corynebacterium türleridir. 11/9/2020 45

b-Geçici flora • Günlük aktiviteler sırasında cilde bulaşan mo’dan oluşur. • Hastaya ait kan, balgam, çeşitli vücut sıvıları ile kontamine araç ve gereçlerden sağlık personelinin eline bulaşırlar. • Hastalık oluşturma potansiyelleri yüksektir ve sağlık personelinin kontamine elleri ile ilişkili çok sayıda salgından sorumludurlar. 11/9/2020 46

El Hijyeni ve “Temiz İşlemler” Hemşirelerin elleri – Hastayı kaldırma, – Nabız, tansiyon ölçme – Hastanın vücut sıcaklığını ölçme – Hastaya dokunma 100 -1000 cfu Hastanın kasığına temas 10 -600 cfu/ml P. mirabilis üremesi Klebsiella spp ile kontaminasyon 47

El Yıkama 1. Sosyal El Yıkama 2. Hijyenik El Yıkama 3. Cerrahi El Yıkama

1. Sosyal El Yıkama Sabun ile ellerin 20 sn kadar yıkanmasıdır.

SOSYAL EL YIKAMA • Yiyecek tatmadan, yemek yemeden ve hastaya yemek yedirmeden önce, • Tuvalete gittikten sonra, • Hasta bakımına başlamadan önce (yatak banyosu, ağız bakımı. . gibi) • Ellerin her kirlenmesinde yapılmalıdır.

2. Hijyenik El Yıkama-1 • Hijyenik el yıkamada antibakteriyel etkinliği olan ajanlar (iyodofor, klorheksidin vb. ) kullanılmaktadır. • Hijyenik el yıkamada öncelikle musluk kağıt havlu ile açılarak eller ılık su ile ıslandıktan sonra 3 -5 m. L tercih edilen sabun alınarak en az 15 saniye uygun teknikle yıkanmalıdır.

2. Hijyenik El Yıkama-2 • Hijyenik el yıkamada ellerin iç yüzeyleri, ellerin dış yüzeyleri, parmak araları, baş parmak arası, avuç ortası ve bileklere özen gösterilmeli, sırayla bu yüzeylere iyice friksiyon yapılmalıdır. • Eller ılık su altında iyice durulanmalı ve kağıt havlu ile kurulanmalıdır. • Musluk yine kağıt havlu ile kapatılmalıdır.

2. Hijyenik el yıkama-3 • Tüm invaziv girişimlerden önce, • Bağışıklık sistemi baskılanmış hastalarla temastan önce, • Yaralara, üretral kateterlere dokunmadan önce ve dokunduktan sonra, • Eldiven takmadan önce ve eldiveni çıkardıktan sonra, • Kanlı atıklarla temas ve mikrobik kontaminasyonu düşündürebilecek durumlarla karşılaşıldıktan sonra yapılmalıdır.

3. Cerrahi El Yıkama • Geçici mikroorganizmaların öldürülüp, uzaklaştırılması, kalıcı mikroorganizmaların ise mümkün olduğunca azaltılması amacıyla cerrahi ortamda cerrahi tüm girişimler öncesinde ellerin su ve sabunla yıkanarak fırçalanması esasına dayanır. • Tüm cerrahi girişimlerden önce cerrahi el yıkamadan sonra eldiven giyilir.



El Hijyenik el yıkama El antisepsisi El yıkama Cerrahi el hijyeni Normal sabun El Antimikrobiyal Antiseptik antiseptiği sabun Eğitim Birimi 2014 57

Enfeksiyon Kontrol Önlemlerinde En Önemli Unsur El Hijyenidir Neden? ? 11/9/2020 58

SADECE EL YIKAMA İLE HASTANE ENFEKSİYONLARI AZALTILABİLİR 11/9/2020 59

Uygun bir el yıkamada ellerinizdeki mikropların %90’ından kurtulabilirsiniz. 11/9/2020 60
11/9/2020 61

El hijyeninin diğer önemli noktaları • Suni tırnak Ø • Tırnakların uzunluğu tırnak etini geçmemeli

İzolasyon Önlemleri • CDC’nin izolasyon önlemleri konusundaki son kılavuzu 2007 yılında yayınlanmıştır (Guideline for Isolation Precautions: Preventing Transmission of Infectious Agents in Healthcare Settings 2007) 1. Standart önlemler 2. Genişletilmiş önlemler ØSolunum izolasyonu (Airborne precautions) ØDamlacık izolasyonu (Droplet precautions) ØTemas izolasyonu (Contact precautions) ØKoruyucu ortam

1. Standart önlemler-1 • Hastanın tanısına ve enfeksiyonu olup olmadığına bakılmaksızın bütün hastalara uygulanan önlemlerdir.

1. Standart Önlemler-2 • • • Kanla, her türlü vücut sıvısı ve ter dışında her tür vücut salgısı ile, Mukoza ile, Bütünlüğü bozulmuş ciltle temas sırasında steril olmayan ELDİVEN giyilmelidir. Temas sonrasında eldiven çıkarıldıktan sonra EL HİJYENİ sağlanmalıdır. Hasta üzerinde kirli bir alandan temiz bir alana geçerken eldivenler değiştirilerek el hijyeni sağlanmalıdır.

1. Standart Önlemler-3 • • • Vücut sıvı veya salgılarının çevreye sıçrama veya yayılma ihtimali olan durumlarda eldivene ek olarak diğer kişisel korunma malzemeleri (önlük, maske veya gözlük) kullanılmalıdır. Kan ve diğer vücut sıvı/salgılarının çevreye sıçrama/püskürme ihtimali olan durumlarda (endotrakeal aspirasyon, endotrakeal entübasyon, vasküler invaziv girişimler, vb. ) cerrahi maske + gözlük veya siperli maske kullanılmalıdır. Her tür spinal girişim sırasında (miyelogram, lomber ponksiyon, spinal anestezi, vb. ) işlemi yapan kişi cerrahi maske takmalıdır.

1. Standart Önlemler-4 • Solunum hijyeni: – Öksüren/hapşıran hastaların çevreye yayabileceği infeksiyöz partiküllerin Acil Servis’in triyaj veya hasta kabul alanı ve poliklinik alanları gibi giriş noktalarında kontrolünü sağlayabilmek için – Öksüren/hapşıran hastalara ağızlarını kağıt mendil/peçete ille kapatmaları konusunda eğitim verilmeli. – Öksüren/hapşıran hastalara mümkünse cerrahi maske taktırılmalı ve diğer hastalarla aralarında en az bir metre mesafe olacak şekilde yerleştirme yapılmalı

1. Standart Önlemler-5 • Hastaların vücut sıvı/salgıları ile kirlenmiş yüzey/malzemelerle temas ederken eldiven giyilmeli, eldiven çıkarıldıktan sonra el hijyeni sağlanmalıdır. • Kirli malzemelerin transferi, ortamda kontaminasyonuna neden olmayacak şekilde yapılmalıdır.

Standart Önlemler Güvenli Enjeksiyon Uygulamaları • Her tür parenteral enjeksiyon sırasında steril, tek kullanımlık enjektör ucu ve enjektör kullanılmalı, bir kez kullanılmış veya herhangi bir nedenle sterilitesi bozulmuş enjektör / enjektör uçları kesinlikle kullanılmamalıdır.

Standart Önlemler Güvenli Enjeksiyon Uygulamaları • Kullanım sonrasında iğne uçları enjektörden ayrılmamalı, uçlarına kılıf takılmamalı, kıvrılıp bükülmemeli, enjektörler uçları ile birlikte özel kesicidelici alet kutularına atılmalıdır.

Standart Önlemler Güvenli Enjeksiyon Uygulamaları • Kesici-delici aletler, kesici-delici uçları vücudun herhangi bir bölümüne dönük şekilde elden ele tranfer edilmemelidir. • Her tür kesici-delici alet özel kesici-delici alet kutularına atılmalıdır. • Multidoz flakonlara her giriş için yeni ve steril bir enjektör ve enjektör ucu kullanılmalıdır.

Standart Önlemler • Ağızdan ağıza resusitasyondan kaçınılmalı, ambu ve diğer ventilasyon cihazlarının kullanımı tercih edilmelidir. Vücut sıvı ve salgıları ile kirlenme ihtimali olan yüzeyler yakınında (servislerde hastalardan alınan numunelerin bulunduğu masalar, laboratuvarlar, gibi) yiyecek-içecek saklanmamalı ve birşeyler yenilip içilmemelidir. • – İlaç ve/veya mama/gıda saklanan buzdolaplarında vücut sıvısı ve salgısı bulundurulmamalıdır.

Standart Önlemler • Eldiven: – Kan, vücut sıvıları, salgılar ve çıkartılar, kontamine eşyalar, mukozalar ve bütünlüğü bozulmuş deriye dokunmadan önce eldiven giyilmelidir – Aynı hastada farklı girişimler için eldiven değiştirilmelidir. – Kullanımdan sonra hiçbir yere dokunmadan eldivenler çıkarılıp el hijyeni sağlanmalıdır.

Standart Önlemler • Maske, yüz-göz koruyucu: – İşlemler sırasında vücut sıvıları, salgılar, çıkartılar ve kan sıçrama olasılığı olduğunda göz, burun ve ağız mukozasını koruma amaçlı kullanılmalıdır

Standart Önlemler • Önlük: – İşlemler sırasında vücut sıvıları, salgılar, çıkartılar ve kan sıçrayabileceğinden deri ve giysilerin kirlenmesini önlemek için giyilir – Kirlenen önlük dış yüzüne dokunmadan çıkarılmalı ve eller yıkanmalıdır

Standart Önlemler • Hasta bakım malzemeleri: – Kan, vücut sıvıları, salgılar ve çıkartılar, kontamine eşyalar, mukozalar ve deriye dokunmadan, giysiler ve diğer malzemeler, başka hastalar ve çevre kontamine edilmeden uzaklaştırılmalıdır – Bir kullanımlık malzemeler hemen atılmalı, tekrar kullanılacak olanlar uygun yöntemlerle steril/dezenfekte edilmelidir

Standart Önlemler • Yatak çarşafları – Çevreyi kontamine etmeden uygun şekilde çamaşırhaneye gönderilmelidir • Doğrudan ağıza resüsitasyon yaptırılmamalıdır

Koruyucu ekipmanın uygun kullanımı • Giyme sırası – Önlük – Maske – Gözlük-yüz koruyucu – Eldiven

Önlük giyerken • Önlük malzemesi uygulanacak işleme göre seçilmeli • Uygun tip ve boyut seçilmeli • Arkadan bağlanmalı • Eğer çok küçük ise iki tane önlük giyilmeli – Biri önden – Diğeri arkadan

Maske takılırken • Burnu, ağzı ve çeneyi tamamen içine almalıdır • Yüze uygunluk tam olmalı • N 95 gibi özel tip maskeler için yüze uyum testi yapılmalı

Maske takıldıktan sonra • Tükrük veya sekresyonlarla ıslandığı zaman değiştirilmeli • Tekrar kullanılmamalı • Ortak kullanılmamalı

Gözlük-yüz koruyucusu giyilmesi • Gözleri ve yüzü tam olarak kapatmalı • Yüze uygunluk tam olmalı • Yüze oturmalı ancak sıkmamalıdır

Eldiven giyilirken • Eldivenler en son giyilmeli • Doğru tip ve boyutta eldiven seçilmeli • Eldiven giymeden önce eller yıkanmalı veya el dezenfektanı ile ovalanmalı • Önlüğün kol manşetleri üzerine çekilmeli

Eldiven giyildikten sonra; Temizden kirliye doğru çalışılmalı Eldiven ile çalışırken kendine ve çevreye kontamine temas sınırlanmalı Eldivenler tekrar kullanılmamalı Eldiven çıkartıldıktan sonra el hijyeni sağlanmalı ELDİVEN ÜZERİNE EL DEZENFEKTANI UYGULANMAMALI VEYA ELDİVENLİ ELLER YIKANMAMALIDIR.

• Çıkarma sırası – Eldiven – Gözlük-yüz koruyucu – Önlük – Maske

Eldiven çıkarılırken • • Elin üzerinden sıyrılarak içi dışına çevrilir Diğer eldivenli el ile tutulur Eldivensiz parmakla bilekten diğer eldiven sıyrılır İçi dışına çevrilerek her iki eldivenden oluşan küçük bir torba şeklinde atılır

Gözlük-yüz koruyucusu çıkarılırken • Eldivensiz ellerle çıkarılır

Önlük çıkarılırken • Omuz kısımlarından tutulur • Kontamine dış yüz içe doğru çevrilir • Yuvarlayarak katlanır • Çıkarıldığında sadece temiz taraf görünmelidir

Maske çıkarılırken • Maske bağları (önce alttaki) çözülür • Maskenin ön yüzü kontamine olduğu için elle temas etmemelidir • Bağlardan tutularak atılır

İzolasyonlar • • Bulaşıcı hastalık tanısı veya şüphesi olan hastalar, hastaneye yatırılma endikasyonları yönünden dikkatle değerlendirilmeli, mümkün olan her durumda ayaktan tanı ve tedavi hizmeti almaları sağlanmalıdır. Bu hastaların elektif yatışları ertelenmelidir. Hastanede yatan ve bulaşıcı hastalık tanısı/şüphesi olan hastalar uygun izolasyon kategorisine göre izole edilmelidir.

Genişletilmiş Önlemler • • Temas izolasyonu (Contact precautions) Damlacık izolasyonu (Droplet precautions) Solunum izolasyonu (Airborne precautions) Koruyucu ortam


Temas İzolasyonu • Mikroorganizmaların enfekte ya da kolonize hastalardan direkt temas ya da indirekt temasla (enfekte objelerle temas) bulaşmasını engellemek için kullanılır

Temas İzolasyonu • Tek kişilik oda / kohort uygulaması • Hasta ile veya çevresindeki cansız yüzeylerle temas ederken steril olmayan temiz eldiven giyilmelidir. • Hasta ile veya odasındaki yüzeylerle temasın fazla olmasının beklendiği durumlarda, hastada idrar veya gaita inkontinansı olması, ileostomi, kolostomi veya açık drenaj varlığında odaya girerken eldivene ek olarak steril olmayan temiz bir önlük giyilmelidir.

Temas İzolasyonu • Eldiven ve önlüğün hasta odasını terk etmeden önce çıkarılmalıdır. • El hijyeni • Eldiven ve önlük çıkarılıp el hijyeni sağlandıktan sonra hastanın yakın çevresindeki yüzeylerle temas edilmemelidir. • Odalar veya hastalar arasında eşya ve tıbbi malzeme transferi önlenmelidir.

Temas İzolasyonu Endikasyonlar • Epidemiyolojik önem taşıyan çoğul dirençli bakteriler: – – MRSA Acinetobacter P. aeruginosa ESBL-pozitif Klebsiella, E. coli, vb. • Diğer: – C. difficile, enterohemorajik E. Coli 0157: H 7, Shigella, hepatit A, rotavirus – Kutanöz difteri, HSV, impetigo, bit, uyuz, zoster (dissemine veya immünsuprese konakçıda) – Viral/hemorajik infeksiyonlar (Lassa, Ebola, Kırım-Kongo) – RSV, PIV veya enteroviral infeksiyonlar

Temas İzolasyonunun Etkinliği • 33 yataklı bir yenidoğan yoğun bakım ünitesindeki MRSA salgınının kontrolü: -Temas izolasyonu uygulanan hastalardan diğer hastalara bulaş oranı : 0, 009 bulaş/gün -Temas izolasyonu uygulanmayan hastalardan diğer hastalara bulaş oranı : 0, 14 bulaş/gün - Temas izolasyonu bulaş oranını 16 kat azaltıyor.

Damlacık İzolasyonu • Büyük partiküllü (> 5µm) damlacıkların geçişinin önlenmesinde kullanılır. • Partiküller büyük olduğu için yere çöker • Bulaşmanın olması için kaynak ve duyarlı kişi arasında yakın mesafe (yaklaşık 1 m) gereklidir

Damlacık İzolasyonu • Duyarlı kişiye burun-ağız-konjonktiva yoluyla bulaşma olur: – Enfekte hastaların konuşması, öksürmesi ya da burun silmesi, – Aspirasyon, entubasyon, bronkoskopi gibi işlemler sırasında.

Damlacık izolasyonu uygulanması gereken enfeksiyonlar • Damlacık yoluyla yayılan ciddi hastalıklar – İnvaziv H. influenzae tip B infeksiyonu, • menenjit, pnömoni, epiglottit ve sepsis – İnvaziv Neisseria meningitidis infeksiyonu, • menenjit, pnömoni ve sepsis • Damlacık yoluyla yayılan diğer ciddi bakteriyel solunum yolu enfeksiyonları: – – – Difteri, Mycoplasma pneumonia Boğmaca Pnömonik veba Çocuklarda streptokokal (grup A) farenjit, pnömoni ve kızıl

Damlacık izolasyonu uygulanması gereken enfeksiyonlar • Damlacık yoluyla yayılan diğer ciddi viral enfeksiyonlar: – Adenovirus – İnfluenza – Kabakulak – Parvovirüs B 19 – Kızamıkçık – KKHA

Damlacık İzolasyonu • Hasta tek kişilik odaya alınmalıdır • Eğer tek kişilik oda yoksa aynı mikroorganizma ile enfekte ve başka enfeksiyonu olmayan bir hasta ile aynı odayı paylaşabilir • Eğer farklı tanılı hastalarla aynı odayı paylaşması gerekiyorsa yataklar arası mesafe en az 1 m olmalıdır.

Damlacık İzolasyonu • Özel havalandırma gerekmez • Oda kapısı açık olabilir. • Hasta odasına girerken cerrahi maske takılmalıdır. • Sağlık personeli hastaya 1 metreden yakın mesafede çalışırken maske takmalıdır • Hasta çok gerekmedikçe oda dışına çıkmamalıdır. Oda dışına çıkacaksa cerrahi maske ile çıkarılmalıdır

Solunum İzolasyonu • Küçük partiküllerin (<5µm) geçişinin önlenmesinde kullanılır. • Partiküller küçük olduğu için havada asılı kalır • Bu asılı partiküller hava akımıyla çok uzak mesafelere kadar gidebilirler

Solunum izolasyonu uygulanması gereken durumlar • • • Aktif Akc. ve Larinks Tüberkülozu, Kızamık, Su çiçeği Yaygın zoster enfeksiyonu, SARS Viral hemorajik ateş – Ebola, Lassa, Marburg, Kırım-Kongo

Solunum İzolasyonu • Özel havalandırma ya da ventilasyon sistemi gereklidir -Hava akımı koridordan odaya olmalı (negatif basınç) -Saatte 6 -12 kez hava değişimi sağlanmalı • Çok geçerli nedenler olmadıkça hasta oda dışına çıkarılmaz. Çıkması gerekiyorsa cerrahi maske takılır. • Oda kapısı kapalı tutulmalıdır.

Solunum İzolasyonu • Akc. tüberküloz tanısı ya da şüphesi olan hasta odasına girerken N 95 solunum maskesi takılmalıdır • Kızamık, suçiçeği tanısı olan hasta odasına mümkünse bağışık olmayan kişiler girmemelidir. – Mutlaka girmesi gerekiyorsa N 95 solunum maskesi ile girmelidirler.

Diğer Önemli Noktalar • İzolasyon önlemleri ve önemi konusunda sağlık personeli, hastalar ve hasta yakınları Enfeksiyon Kontrol Ekibi tarafından bilgilendirilmelidir. • Önlemlere uyum konusunda gözlem yapılarak, kayıt altına alınmalı ve sonuçlar konusunda geri bildirim verilmelidir.

Koruyucu Ortam • Allojeneik kemik iliği nakli yapılan hastalar engrafman (Kök hücrelerin alıcı kemik iliğine yerleşip kan yapımına başlaması) gerçekleşene kadar koruyucu ortamda izlenmelidir. (odada yapılması mümkün olmayan diagnostik ve terapötik işlemler hariç) • Oda tek kişilik olmalıdır.

Koruyucu Ortam • Odaya giren hava 0, 3 büyüklüğündeki partikülleri filtre edebilen HEPA (High efficiency particulate air filtration) filtrelerinden geçirilmelidir (%99, 97 etkinlik). – Otolog kemik iliği alıcıları için HEPA filtrelerinin gerekliliği, allojeneik kemik iliği alıcılarınınki kadar iyi tanımlanmamıştır.

Koruyucu Ortam • Hasta odası ile oda dışındaki alanlar arasında >2, 5 Pa’lık bir basınç farkı bulunmalı ve saatte 12 hava değişimi sağlanmalıdır. • Filtre edilen havanın akım yönü hastadan koridora doğru olmalıdır (temiz kirli).

Koruyucu Ortam • Dış ortamdan oda içine hava akımını önlemek için odanın izolasyonu iyi yapılmış olmalıdır (duvarlar, tavan, pencereler, elektrik prizleri, vb. ) • Odada toz kontrolü etkin bir şekilde sağlanmalı, tüm yüzeyler kolay silinip temizlenebilir/ dezenfekte edilebilir nitelikte olmalıdır.

Koruyucu Ortam • Odada taze veya kuru çiçek bulundurulmamalıdır. • Hastane içinde veya çevresinde yapım-onarım çalışması var ve hastanın koruyucu ortam dışına çıkması gerekli ise N 95 maskesi takmalıdır.

Özet Duyarlı hastalar ve personel korunmalı Önlemler -El hijyeni -Eldiven kullanımı -İzolasyon önlemleri (Kan, temas, damlacık, havayolu) Önlemlere uyma -Hastalar, ziyaretçiler ve sağlık çalışanı Eğitim

SORU İzolasyonu tanımlayarak genişletilmiş izolasyon önlemlerini açıklayınız.